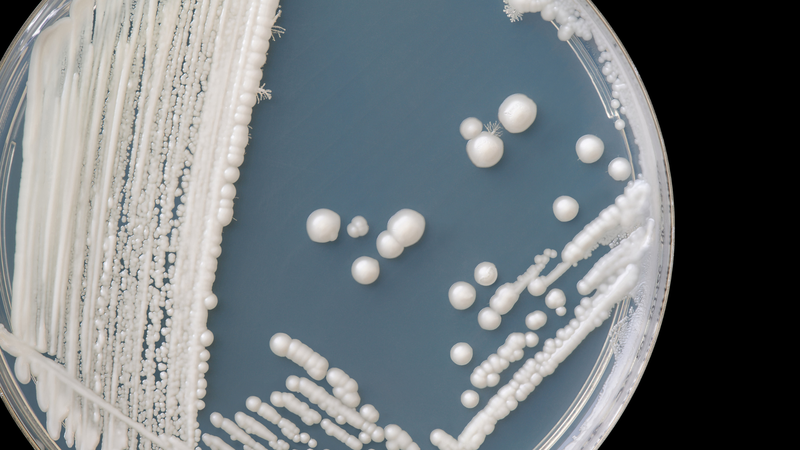
Khí hư vón cục báo hiệu tình trạng sức khỏe như thế nào? Cách phòng ngừa khí hư vón cục 2

Dược sĩ chuyên khoa Dược lý - Dược lâm sàng. Tốt nghiệp 2 trường đại học Mở và Y Dược TP. Hồ Chí Minh. Có kinh nghiệm nghiên cứu về lĩnh vực sức khỏe, đạt được nhiều giải thưởng khoa học. Hiện là Dược sĩ chuyên môn phụ trách xây dựng nội dung và triển khai dự án đào tạo - Hội đồng chuyên môn tại Nhà thuốc Long Châu.
Khí hư vón cục báo hiệu tình trạng sức khỏe như thế nào? Cách phòng ngừa khí hư vón cục
Bảo Yến
05/05/2025
Mặc định
Lớn hơn
Tình trạng khí hư vón cục là vấn đề phụ khoa mà khá nhiều chị em phụ nữ mắc phải. Đây là dấu hiệu cảnh báo cơ thể có thể đang có nguy cơ đối mặt với các bệnh lý phụ khoa. Vậy khí hư vón cục báo hiệu những bệnh lý cụ thể nào? Hãy cùng Nhà thuốc Long Châu tìm hiểu thêm về khí hư ở nữ giới qua bài viết sau đây nhé!
Khí hư vón cục là một dấu hiệu cảnh báo về tình trạng viêm nhiễm phụ khoa ở phụ nữ. Không chỉ gây ảnh hưởng đến cuộc sống sinh hoạt hàng ngày, tình trạng ra nhiều khí hư vón cục cũng khiến không ít chị em cảm thấy tự ti trong chuyện chăn gối vợ chồng. Hãy cùng tìm hiểu thêm về tình trạng khí hư vón cục và cách phòng tránh nó qua bài viết sau đây nhé!
Khí hư là gì?
Khí hư là dạng dịch nhầy tiết ra ở vùng kín của chị em phụ nữ, tình trạng ra khí hư có thể bắt đầu từ độ tuổi dậy thì và kéo dài đến khi giai đoạn mãn kinh kết thúc. Vì vậy, khí hư tiết ra thường xuyên ở vùng âm đạo là hiện tượng bình thường của cơ thể. Khí hư bình thường sẽ có màu trong suốt hoặc trắng đục như lòng trắng trứng, không ngứa ngáy, hơi dai và có mùi tanh nhẹ. Chị em cũng nên chú ý đến những thay đổi bất thường của khí hư để nhận biết nguy cơ mắc một số bệnh lý phụ khoa. Chẳng hạn như khí hư vón cục là dấu hiệu của bệnh viêm nhiễm âm đạo,...

Khí hư có ý nghĩa rất quan trọng đối với vùng kín, không chỉ có chức năng cân bằng nồng độ PH vùng kín để giúp sản sinh lợi khuẩn, khí hư còn giúp giữ ẩm âm đạo và ngăn ngừa những vi khuẩn có hại xâm nhập. Ngoài ra, khí hư cũng mang đến trải nghiệm quan hệ tình dục thăng hoa hơn nhờ khả năng bôi trơn vùng kín, giúp tinh trùng dễ dàng xâm nhập vào sâu bên trong âm đạo để thụ thai. Trước mỗi chu kỳ kinh nguyệt, lượng dịch tiết âm đạo thường chảy ra nhiều hơn. Khí hư tiết nhiều hay ít còn tùy vào các thời điểm khác nhau trong chu kỳ kinh nguyệt cũng như hàm lượng estrogen cơ thể sản sinh. Các trường hợp chị em có thể tiết nhiều khí hư hơn mức bình thường bao gồm:
- Căng thẳng, stress kéo dài.
- Khi âm đạo bị kích thích trong quá trình sinh hoạt tình dục.
- Khí hư thường tiết ra nhiều hơn trong thai kỳ, có thể tiết thành từng dòng hoặc sợi dài.
- Trong thời kỳ kinh nguyệt, cơ thể sản sinh nhiều estrogen hơn bình thường.
Khí hư vón cục báo hiệu tình trạng sức khỏe như thế nào?
Vậy hiện tượng khí hư vón cục là biểu hiện của những bệnh lý nào? Các bác sĩ phụ khoa đã chỉ ra rằng khí hư vón cục không phải là một tình trạng sức khỏe nghiêm trọng. Tuy vậy, nếu hiện tượng này kéo dài từ 5 - 7 ngày, bạn nên tìm đến sự hỗ trợ của bác sĩ vì đây có thể là biểu hiện của một số bệnh lý về bộ phận sinh dục. Hiện tượng khí hư có mùi hôi, vón cục, vùng kín thường xuyên xuất hiện cảm giác ngứa ngáy là báo hiệu của một số tình trạng sức khỏe như sau:
Nhiễm nấm Candida
Nhiễm nấm Candida là một bệnh lý phụ khoa phổ biến ở phụ nữ. Theo Bộ Y Tế, có khoảng 70% nữ giới mắc phải căn bệnh này, 90% phụ nữ bị viêm phụ khoa xuất phát từ tình trạng nhiễm vi khuẩn nấm Candida. Khi bị vi khuẩn nấm Candida xâm nhập, âm đạo thường tiết khí hư vón cục hoặc khí hư dạng bã đậu với màu sắc bất thường và mùi hôi khó chịu. Người bệnh có thể cảm thấy ngứa ngáy, đau rát âm đạo nhiều hơn vào ban đêm.
Viêm phần phụ
Những bạn nữ thường xuyên không vệ sinh vùng kín sạch sẽ dễ mắc bệnh viêm phần phụ. Mặt khác, việc quan hệ tình dục không an toàn, lành mạnh cũng tạo điều kiện cho vi khuẩn xâm nhập và gây bệnh. Đặc biệt với những bạn nữ có thói quen quan hệ tình dục bằng miệng, quan hệ không sử dụng biện pháp phòng tránh, quan hệ với nhiều người,...
Khi mắc bệnh viêm phần phụ, người bệnh thường gặp phải tình trạng tiết nhiều khí hư vón cục màu trắng kèm theo dịch mủ màu vàng và mùi hôi. Người bệnh cũng thường sẽ bị đau bụng dưới và sốt nhẹ. Tình trạng này kéo dài có thể gây ảnh hưởng đến khả năng sinh sản cũng như dẫn đến các biến chứng nghiêm trọng khác đối với sức khỏe.
Viêm lộ tuyến cổ tử cung
Khí hư vón cục cũng là dấu hiệu của bệnh viêm lộ tuyến cổ tử cung. Để phân biệt triệu chứng này với các bệnh lý khác, bạn có thể đánh giá dựa trên một số dấu hiệu đi kèm như khí hư màu đục như sữa, tạo thành từng mảng đặc và có mùi hôi. Ngoài ra, khi quan hệ tình dục, người bệnh có thể bị chảy máu tử cung (có thể ít hoặc nhiều). Theo các bác sĩ phụ khoa, khí hư có mùi hôi càng nồng thể hiện bệnh lý đang chuyển biến ngày càng nặng hơn.
Viêm vùng chậu
Bệnh lý viêm vùng chậu được gọi tắt là PID, đây là một căn bệnh về sự nhiễm trùng vùng kín. Nguyên nhân gây bệnh thường là do vi khuẩn tấn công vào âm đạo hoặc các bộ phận liên quan về sinh sản khác. Người mắc bệnh viêm vùng chậu thường có những triệu chứng như khí hư vón cục kèm mùi tanh khó chịu. Người bệnh cũng có thể gặp phải tình trạng đau bụng dưới, đau rát tử cung khi quan hệ, ra máu âm đạo.

Cách phòng ngừa khí hư vón cục
Để giảm thiểu nguy cơ mắc các bệnh lý phụ khoa, chị em phụ nữ cần chủ động phòng bệnh. Sau đây là một số cách phòng ngừa khí hư vón cục bạn có thể tham khảo:
- Vệ sinh vùng kín thường xuyên và đảm bảo vùng kín luôn sạch sẽ.
- Hạn chế thụt rửa sâu bên trong âm đạo.
- Nên có biện pháp bảo vệ an toàn khi quan hệ tình dục.
- Tuyệt đối không quan hệ tình dục qua đường miệng.
- Chỉ nên quan hệ tình dục với một đối tác để tránh nguy cơ nhiễm bệnh từ nhiều người.
- Trong chu kỳ kinh nguyệt, các bạn nữ nên thay băng vệ sinh thường xuyên.
- Xây dựng thói quen rèn luyện cơ thể để tăng cường sức đề kháng.
- Bổ sung đủ nước mỗi ngày.
- Hạn chế thức khuya, ngủ đủ giấc mỗi ngày.
- Hạn chế căng thẳng kéo dài, giữ tinh thần thoải mái.
- Kiểm tra sức khỏe phụ khoa định kỳ, ít nhất mỗi năm một lần.

Hy vọng bài viết trên đã cung cấp cho bạn những thông tin hữu ích về tình trạng khí hư vón cục và những bệnh lý liên quan đến nó. Chị em phụ nữ nên chủ động phòng ngừa các bệnh lý phụ khoa để bảo vệ sức khỏe sinh sản cũng như sức khỏe tổng quan của mình. Hãy tìm đến sự hỗ trợ của bác sĩ ngay khi nhận thấy dấu hiệu khí hư bất thường bạn nhé!
Có thể bạn quan tâm
Các bài viết liên quan
Ra dịch trắng trong có phải dấu hiệu bất thường không?
Khí hư khi rụng trứng có đặc điểm gì? Phân biệt khí hư bất thường
Ra khí hư có mùi cá ươn có sao không? Nguyên nhân và cách xử lý
Kinh nghiệm chữa lạc nội mạc tử cung người bệnh cần biết
Co thắt tử cung khi không mang thai có sao không?
Cách hỗ trợ chữa viêm âm đạo tại nhà an toàn
Huyết trắng là gì? Các bệnh lý phổ biến gây huyết trắng bất thường
Viêm phụ khoa có tiêm HPV được không? Lưu ý quan trọng phụ nữ cần biết
Loạn khuẩn âm đạo là gì? Ảnh hưởng gì đến sức khỏe phụ nữ?
Dấu hiệu viêm lộ tuyến cổ tử cung qua từng cấp độ cần nhận biết sớm
:format(webp)/Option_1_2_2d9677e5fd.png)
:format(webp)/Option_1_1_2a84e0cd00.png)
:format(webp)/tran_huynh_minh_nhat_905ca436dd.png)